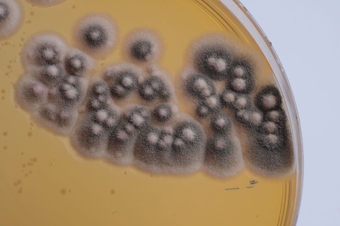

Noun: The study of the forms and structures of organisms.
Adjective: Relating to morphology.
Verb: To study the morphology of something.
The word "morphology" comes from the Greek words "morphē" (meaning "form") and "logos" (meaning "study of"). The word "morphology" was first used in English in the 19th century to describe the study of the forms and structures of organisms.
What is morphology the study of?
Question:
Define the term "morphology" in the context of biology and explain its significance in the study of organisms. Provide examples to illustrate different aspects of morphology.
Answer:
Morphology in biology refers to the study of the physical structure, form, and appearance of organisms, including their internal and external characteristics. It involves analysing the shapes, sizes, colours, and arrangements of various body parts to understand their functions and evolutionary adaptations.
Morphology is essential in the study of organisms because it provides valuable insights into their biology, behaviour, and evolutionary relationships. By examining an organism's morphology, scientists can infer its habitat, diet, locomotion, and reproductive strategies.
For example, in birds, the beak's shape can indicate their feeding preferences. Long, curved beaks are adapted for probing flowers, while short, strong beaks are ideal for cracking seeds. Similarly, in insects, the morphology of wings can reveal their flying capabilities. Dragonflies have large, strong wings for swift flight, while butterflies' delicate wings enable precise manoeuvring.
In plants, leaf morphology varies widely. Needle-like leaves of pine trees reduce water loss, while broad leaves of deciduous trees maximize photosynthesis. The arrangement of petals, stamens, and pistils in flowers is crucial for pollination and reproduction.